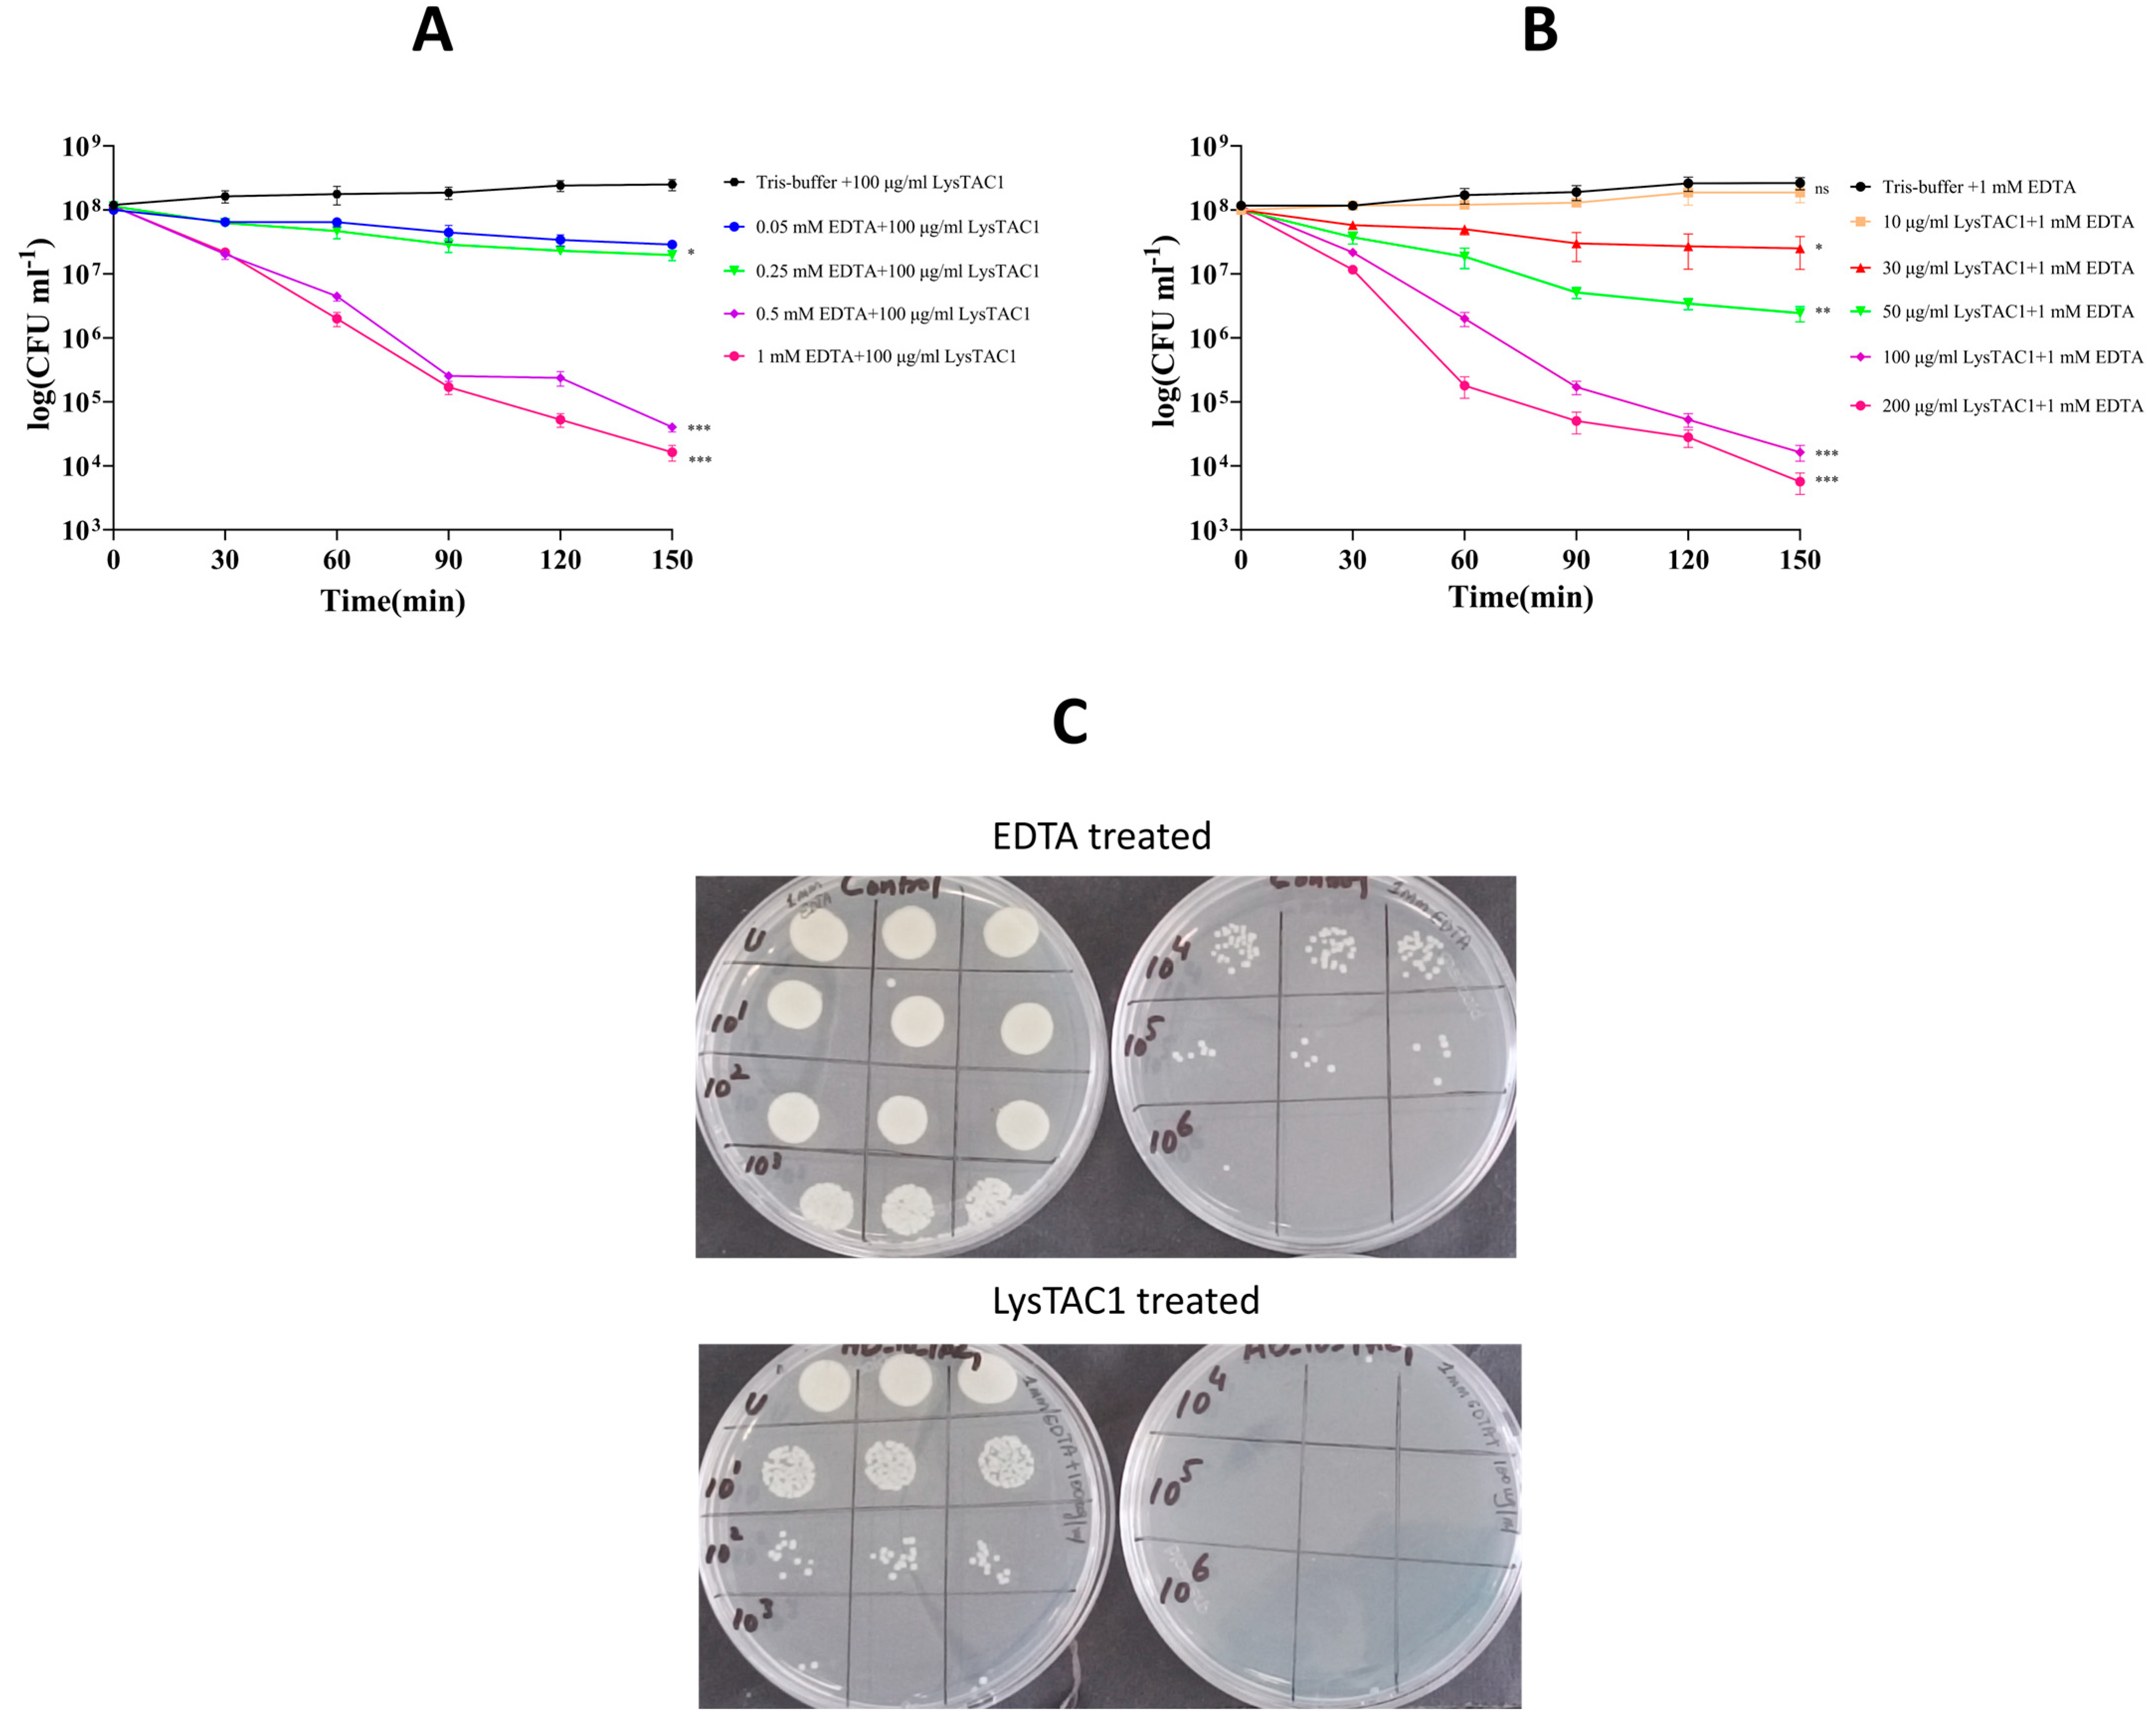

In Vitro Antibacterial Efficacy of Recombinant Phage-Derived Endolysin LysTAC1 Against Carbapenem-Resistant Acinetobacter baumannii
Abstract
1. Introduction
2. Results
2.1. Molecular Identification and Antibiotic Susceptibility Pattern of A. baumannii Clinical Isolates
2.2. Bioinformatic Analysis of LysTAC1
2.3. Molecular Docking of LysTAC1
2.4. Over-Expression and Purification of LysTAC1
2.5. Antibacterial Activity of LysTAC1
2.5.1. Muralytic Activity
2.5.2. LysTAC1 Antibacterial Activity with EDTA
2.5.3. LysTAC1 Dose Response Activity
2.5.4. LysTAC1 Efficacy Across Bacterial Growth Phases
2.5.5. LysTAC1 Against Diverse Bacterial Strains
2.5.6. TEM of LysTAC1-Treated A. baumannii
2.6. Stability of LysTAC1
3. Discussion
4. Materials and Methods
4.1. Strains and Culture Conditions
4.2. Molecular Identification and Antibiotic Susceptibility of A. baumannii Clinical Isolates
4.3. Identification and Sequence Analysis of LysTAC1
4.4. Molecular Docking of LysTAC1
4.5. Synthesis, Molecular Cloning, and Over-Expression of LysTAC1
4.6. Western Blot Analysis
4.7. LysTAC1 Purification
4.8. Antibacterial Characterization of LysTAC1
4.8.1. Muralytic Activity
4.8.2. LysTAC1 Antibacterial Activity with EDTA
4.8.3. LysTAC1 Dose Response Activity
4.8.4. LysTAC1 Efficacy Across Bacterial Growth Phases
4.8.5. LysTAC1 Against Diverse Bacterial Strains
4.8.6. TEM of LysTAC1 Treated A. baumannii
4.9. Stability of LysTAC1
4.10. Statistical Analysis
5. Conclusions
Supplementary Materials
Author Contributions
Funding
Institutional Review Board Statement
Informed Consent Statement
Data Availability statement
Acknowledgments
Conflicts of Interest
References
- Ma, C.; McClean, S. Mapping Global Prevalence of Acinetobacter baumannii and Recent Vaccine Development to Tackle It. Vaccines 2021, 9, 570. [Google Scholar] [CrossRef]
- Rossau, R.; Van Landschoot, A.; Gillis, M.; De Ley, J. Taxonomy of Moraxellaceae fam. nov., a New Bacterial Family to Accommodate the Genera Moraxella, Acinetobacter, and Psychrobacter and Related Organisms. Int. J. Syst. Evol. Microbiol. 1991, 41, 310–319. [Google Scholar] [CrossRef]
- Smith, M.G.; Gianoulis, T.A.; Pukatzki, S.; Mekalanos, J.J.; Ornston, L.N.; Gerstein, M.; Snyder, M. New insights into Acinetobacter baumannii pathogenesis revealed by high-density pyrosequencing and transposon mutagenesis. Genes Dev. 2007, 21, 601–614. [Google Scholar] [CrossRef] [PubMed]
- Nemec, A.; Krizova, L.; Maixnerova, M.; van der Reijden, T.J.; Deschaght, P.; Passet, V.; Vaneechoutte, M.; Brisse, S.; Dijkshoorn, L. Genotypic and phenotypic characterization of the Acinetobacter calcoaceticus-Acinetobacter baumannii complex with the proposal of Acinetobacter pittii sp. nov. (formerly Acinetobacter genomic species 3) and Acinetobacter nosocomialis sp. nov. (formerly Acinetobacter genomic species 13TU). Res. Microbiol. 2011, 162, 393–404. [Google Scholar] [CrossRef] [PubMed]
- Nemec, A.; Krizova, L.; Maixnerova, M.; Sedo, O.; Brisse, S.; Higgins, P.G. Acinetobacter seifertii sp. nov., a member of the Acinetobacter calcoaceticus-Acinetobacter baumannii complex isolated from human clinical specimens. Int. J. Syst. Evol. Microbiol. 2015, 65, 934–942. [Google Scholar] [CrossRef] [PubMed]
- Cosgaya, C.; Marí-Almirall, M.; Van Assche, A.; Fernández-Orth, D.; Mosqueda, N.; Telli, M.; Huys, G.; Higgins, P.G.; Seifert, H.; Lievens, B.; et al. Acinetobacter dijkshoorniae sp. nov., a member of the Acinetobacter calcoaceticus-Acinetobacter baumannii complex mainly recovered from clinical samples in different countries. Int. J. Syst. Evol. Microbiol. 2016, 66, 4105–4111. [Google Scholar] [CrossRef]
- Harding, C.M.; Hennon, S.W.; Feldman, M.F. Uncovering the mechanisms of Acinetobacter baumannii virulence. Nat. Rev. Microbiol. 2018, 16, 91–102. [Google Scholar] [CrossRef]
- Rooney, A.P.; Dunlap, C.A.; Flor-Weiler, L.B. Acinetobacter lactucae sp. nov., isolated from iceberg lettuce (Asteraceae: Lactuca sativa). Int. J. Syst. Evol. Microbiol. 2016, 66, 3566–3572. [Google Scholar] [CrossRef]
- Boo, T.W.; Walsh, F.; Crowley, B. Molecular characterization of carbapenem-resistant Acinetobacter species in an Irish university hospital: Predominance of Acinetobacter genomic species 3. J. Med. Microbiol. 2009, 58, 209–216. [Google Scholar] [CrossRef]
- Zhang, H.Z.; Zhang, J.S.; Qiao, L. The Acinetobacter baumannii group: A systemic review. World J. Emerg. Med. 2013, 4, 169–174. [Google Scholar] [CrossRef]
- Lee, Y.C.; Huang, Y.T.; Tan, C.K.; Kuo, Y.W.; Liao, C.H.; Lee, P.I.; Hsueh, P.R. Acinetobacter baumannii and Acinetobacter genospecies 13TU and 3 bacteraemia: Comparison of clinical features, prognostic factors and outcomes. J. Antimicrob. Chemother. 2011, 66, 1839–1846. [Google Scholar] [CrossRef] [PubMed]
- Wisplinghoff, H.; Paulus, T.; Lugenheim, M.; Stefanik, D.; Higgins, P.G.; Edmond, M.B.; Wenzel, R.P.; Seifert, H. Nosocomial bloodstream infections due to Acinetobacter baumannii, Acinetobacter pittii and Acinetobacter nosocomialis in the United States. J. Infect. 2012, 64, 282–290. [Google Scholar] [CrossRef]
- Peleg, A.Y.; Seifert, H.; Paterson, D.L. Acinetobacter baumannii: Emergence of a successful pathogen. Clin. Microbiol. Rev. 2008, 21, 538–582. [Google Scholar] [CrossRef]
- Dijkshoorn, L.; Nemec, A.; Seifert, H. An increasing threat in hospitals: Multidrug-resistant Acinetobacter baumannii. Nat. Rev. Microbiol. 2007, 5, 939–951. [Google Scholar] [CrossRef]
- Al-Kadmy, I.M.S.; Ali, A.N.M.; Salman, I.M.A.; Khazaal, S.S. Molecular characterization of Acinetobacter baumannii isolated from Iraqi hospital environment. New Microbes New Infect. 2018, 21, 51–57. [Google Scholar] [CrossRef]
- Kyriakidis, I.; Vasileiou, E.; Pana, Z.D.; Tragiannidis, A. Acinetobacter baumannii Antibiotic Resistance Mechanisms. Pathogens 2021, 10, 373. [Google Scholar] [CrossRef]
- Liu, X.; Wu, X.; Tang, J.; Zhang, L.; Jia, X. Trends and Development in the Antibiotic-Resistance of Acinetobacter baumannii: A Scientometric Research Study (1991–2019). Infect. Drug Resist. 2020, 13, 3195–3208. [Google Scholar] [CrossRef]
- Kazi, M.; Annapure, U.S. Bacteriophage biocontrol of foodborne pathogens. J. Food Sci. Technol. 2016, 53, 1355–1362. [Google Scholar] [CrossRef]
- Kim, S.; Rahman, M.; Seol, S.Y.; Yoon, S.S.; Kim, J. Pseudomonas aeruginosa bacteriophage PA1Ø requires type IV pili for infection and shows broad bactericidal and biofilm removal activities. Appl. Env. Microbiol. 2012, 78, 6380–6385. [Google Scholar] [CrossRef] [PubMed]
- Aranaga, C.; Pantoja, L.D.; Martínez, E.A.; Falco, A. Phage Therapy in the Era of Multidrug Resistance in Bacteria: A Systematic Review. Int. J. Mol. Sci. 2022, 23, 4577. [Google Scholar] [CrossRef] [PubMed]
- Loc-Carrillo, C.; Abedon, S.T. Pros and cons of phage therapy. Bacteriophage 2011, 1, 111–114. [Google Scholar] [CrossRef] [PubMed]
- Principi, N.; Silvestri, E.; Esposito, S. Advantages and Limitations of Bacteriophages for the Treatment of Bacterial Infections. Front. Pharmacol. 2019, 10, 513. [Google Scholar] [CrossRef]
- Wu, M.; Hu, K.; Xie, Y.; Liu, Y.; Mu, D.; Guo, H.; Zhang, Z.; Zhang, Y.; Chang, D.; Shi, Y. A Novel Phage PD-6A3, and Its Endolysin Ply6A3, With Extended Lytic Activity Against Acinetobacter baumannii. Front. Microbiol. 2018, 9, 3302. [Google Scholar] [CrossRef]
- Pires, D.P.; Costa, A.R.; Pinto, G.; Meneses, L.; Azeredo, J. Current challenges and future opportunities of phage therapy. FEMS Microbiol. Rev. 2020, 44, 684–700. [Google Scholar] [CrossRef]
- Lin, J.; Du, F.; Long, M.; Li, P. Limitations of Phage Therapy and Corresponding Optimization Strategies: A Review. Molecules 2022, 27, 1857. [Google Scholar] [CrossRef]
- Goodridge, L.D. Designing phage therapeutics. Curr. Pharm. Biotechnol. 2010, 11, 15–27. [Google Scholar] [CrossRef]
- Abedon, S.T.; Thomas-Abedon, C. Phage therapy pharmacology. Curr. Pharm. Biotechnol. 2010, 11, 28–47. [Google Scholar] [CrossRef]
- Hyman, P.; Abedon, S.T. Bacteriophage host range and bacterial resistance. Adv. Appl. Microbiol. 2010, 70, 217–248. [Google Scholar] [CrossRef] [PubMed]
- Viscardi, M.; Perugini, A.G.; Auriemma, C.; Capuano, F.; Morabito, S.; Kim, K.P.; Loessner, M.J.; Iovane, G. Isolation and characterisation of two novel coliphages with high potential to control antibiotic-resistant pathogenic Escherichia coli (EHEC and EPEC). Int. J. Antimicrob. Agents 2008, 31, 152–157. [Google Scholar] [CrossRef]
- Lenneman, B.R.; Fernbach, J.; Loessner, M.J.; Lu, T.K.; Kilcher, S. Enhancing phage therapy through synthetic biology and genome engineering. Curr. Opin. Biotechnol. 2021, 68, 151–159. [Google Scholar] [CrossRef] [PubMed]
- Morrisette, T.; Kebriaei, R.; Lev, K.L.; Morales, S.; Rybak, M.J. Bacteriophage Therapeutics: A Primer for Clinicians on Phage-Antibiotic Combinations. Pharmacotherapy 2020, 40, 153–168. [Google Scholar] [CrossRef]
- Grygorcewicz, B.; Roszak, M.; Golec, P.; Śleboda-Taront, D.; Łubowska, N.; Górska, M.; Jursa-Kulesza, J.; Rakoczy, R.; Wojciuk, B.; Dołęgowska, B. Antibiotics Act with vB_AbaP_AGC01 Phage against Acinetobacter baumannii in Human Heat-Inactivated Plasma Blood and Galleria mellonella Models. Int. J. Mol. Sci. 2020, 21, 4390. [Google Scholar] [CrossRef]
- Akturk, E.; Oliveira, H.; Santos, S.B.; Costa, S.; Kuyumcu, S.; Melo, L.D.R.; Azeredo, J. Synergistic Action of Phage and Antibiotics: Parameters to Enhance the Killing Efficacy Against Mono and Dual-Species Biofilms. Antibiotics 2019, 8, 103. [Google Scholar] [CrossRef]
- Sharma, U.; Vipra, A.; Channabasappa, S. Phage-derived lysins as potential agents for eradicating biofilms and persisters. Drug Discov. Today 2018, 23, 848–856. [Google Scholar] [CrossRef] [PubMed]
- Vázquez, R.; García, E.; García, P. Phage Lysins for Fighting Bacterial Respiratory Infections: A New Generation of Antimicrobials. Front. Immunol. 2018, 9, 2252. [Google Scholar] [CrossRef] [PubMed]
- Peng, S.-Y.; You, R.-I.; Lai, M.-J.; Lin, N.-T.; Chen, L.-K.; Chang, K.-C. Highly potent antimicrobial modified peptides derived from the Acinetobacter baumannii phage endolysin LysAB2. Sci. Rep. 2017, 7, 11477. [Google Scholar] [CrossRef] [PubMed]
- Islam, M.M.; Kim, D.; Kim, K.; Park, S.J.; Akter, S.; Kim, J.; Bang, S.; Kim, S.; Kim, J.; Lee, J.C.; et al. Engineering of lysin by fusion of antimicrobial peptide (cecropin A) enhances its antibacterial properties against multidrug-resistant Acinetobacter baumannii. Front. Microbiol. 2022, 13, 988522. [Google Scholar] [CrossRef] [PubMed]
- Garcia Torres, S.; Henrich, D.; Verboket, R.D.; Marzi, I.; Hahne, G.; Kempf, V.A.J.; Göttig, S. Bactericidal Effect of a Novel Phage Endolysin Targeting Multi-Drug-Resistant Acinetobacter baumannii. Antibiotics 2025, 14, 162. [Google Scholar] [CrossRef]
- Abdelkader, K.; Gutiérrez, D.; Tamés-Caunedo, H.; Ruas-Madiedo, P.; Safaan, A.; Khairalla Ahmed, S.; Gaber, Y.; Dishisha, T.; Briers, Y. Engineering a Lysin with Intrinsic Antibacterial Activity (LysMK34) by Cecropin A Fusion Enhances Its Antibacterial Properties against Acinetobacter baumannii. Appl. Environ. Microbiol. 2022, 88, e01515-21. [Google Scholar] [CrossRef]
- Gondil, V.S.; Harjai, K.; Chhibber, S. Endolysins as emerging alternative therapeutic agents to counter drug-resistant infections. Int. J. Antimicrob. Agents 2020, 55, 105844. [Google Scholar] [CrossRef]
- Tafoya, D.A.; Hildenbrand, Z.L.; Herrera, N.; Molugu, S.K.; Mesyanzhinov, V.V.; Miroshnikov, K.A.; Bernal, R.A. Enzymatic characterization of a lysin encoded by bacteriophage EL. Bacteriophage 2013, 3, e25449. [Google Scholar] [CrossRef] [PubMed]
- Maciejewska, B.; Olszak, T.; Drulis-Kawa, Z. Applications of bacteriophages versus phage enzymes to combat and cure bacterial infections: An ambitious and also a realistic application? Appl. Microbiol. Biotechnol. 2018, 102, 2563–2581. [Google Scholar] [CrossRef]
- Jun, S.Y.; Jung, G.M.; Yoon, S.J.; Choi, Y.J.; Koh, W.S.; Moon, K.S.; Kang, S.H. Preclinical safety evaluation of intravenously administered SAL200 containing the recombinant phage endolysin SAL-1 as a pharmaceutical ingredient. Antimicrob. Agents Chemother. 2014, 58, 2084–2088. [Google Scholar] [CrossRef]
- Schirmeier, E.; Zimmermann, P.; Hofmann, V.; Biebl, M.; Gerstmans, H.; Maervoet, V.E.T.; Briers, Y. Inhibitory and bactericidal effect of Artilysin(®) Art-175 against colistin-resistant mcr-1-positive Escherichia coli isolates. Int. J. Antimicrob. Agents 2018, 51, 528–529. [Google Scholar] [CrossRef]
- Wang, Z.; Kong, L.; Liu, Y.; Fu, Q.; Cui, Z.; Wang, J.; Ma, J.; Wang, H.; Yan, Y.; Sun, J. A Phage Lysin Fused to a Cell-Penetrating Peptide Kills Intracellular Methicillin-Resistant Staphylococcus aureus in Keratinocytes and Has Potential as a Treatment for Skin Infections in Mice. Appl. Environ. Microbiol. 2018, 84, e00380-18. [Google Scholar] [CrossRef]
- Schmelcher, M.; Donovan, D.M.; Loessner, M.J. Bacteriophage endolysins as novel antimicrobials. Future Microbiol. 2012, 7, 1147–1171. [Google Scholar] [CrossRef]
- Nikaido, H. Molecular basis of bacterial outer membrane permeability revisited. Microbiol. Mol. Biol. Rev. 2003, 67, 593–656. [Google Scholar] [CrossRef]
- Caroff, M.; Karibian, D. Structure of bacterial lipopolysaccharides. Carbohydr. Res. 2003, 338, 2431–2447. [Google Scholar] [CrossRef]
- Erridge, C.; Bennett-Guerrero, E.; Poxton, I.R. Structure and function of lipopolysaccharides. Microbes Infect. 2002, 4, 837–851. [Google Scholar] [CrossRef] [PubMed]
- Nilsson, C.; Skoglund, A.; Moran, A.P.; Annuk, H.; Engstrand, L.; Normark, S. Lipopolysaccharide diversity evolving in Helicobacter pylori communities through genetic modifications in fucosyltransferases. PLoS ONE 2008, 3, e3811. [Google Scholar] [CrossRef] [PubMed]
- Raetz, C.R.; Whitfield, C. Lipopolysaccharide endotoxins. Annu. Rev. Biochem. 2002, 71, 635–700. [Google Scholar] [CrossRef]
- Vaara, M. Agents that increase the permeability of the outer membrane. Microbiol. Rev. 1992, 56, 395–411. [Google Scholar] [CrossRef]
- Schneck, E.; Schubert, T.; Konovalov, O.V.; Quinn, B.E.; Gutsmann, T.; Brandenburg, K.; Oliveira, R.G.; Pink, D.A.; Tanaka, M. Quantitative determination of ion distributions in bacterial lipopolysaccharide membranes by grazing-incidence X-ray fluorescence. Proc. Natl. Acad. Sci. USA 2010, 107, 9147–9151. [Google Scholar] [CrossRef]
- Leive, L. Release of lipopolysaccharide by EDTA treatment of E. coli. Biochem. Biophys. Res. Commun. 1965, 21, 290–296. [Google Scholar] [CrossRef]
- Chaudhary, M.; Payasi, A. Role of EDTA and CSE1034 in curli formation and biofilm eradication of Klebsiella pneumoniae: A comparison with other drugs. J. Antibiot. 2012, 65, 631–633. [Google Scholar] [CrossRef]
- Briers, Y.; Walmagh, M.; Van Puyenbroeck, V.; Cornelissen, A.; Cenens, W.; Aertsen, A.; Oliveira, H.; Azeredo, J.; Verween, G.; Pirnay, J.P.; et al. Engineered endolysin-based “Artilysins” to combat multidrug-resistant gram-negative pathogens. mBio 2014, 5, e01379-14. [Google Scholar] [CrossRef]
- Guo, M.; Feng, C.; Ren, J.; Zhuang, X.; Zhang, Y.; Zhu, Y.; Dong, K.; He, P.; Guo, X.; Qin, J. A Novel Antimicrobial Endolysin, LysPA26, against Pseudomonas aeruginosa. Front. Microbiol. 2017, 8, 293. [Google Scholar] [CrossRef] [PubMed]
- Yang, H.; Wang, M.; Yu, J.; Wei, H. Antibacterial Activity of a Novel Peptide-Modified Lysin Against Acinetobacter baumannii and Pseudomonas aeruginosa. Front. Microbiol. 2015, 6, 1471. [Google Scholar] [CrossRef] [PubMed]
- Asif, M.; Alvi, I.A.; Tabassum, R.; Rehman, S.U. TAC1, an unclassified bacteriophage of the family Myoviridae infecting Acinetobacter baumannii with a large burst size and a short latent period. Arch. Virol. 2020, 165, 419–424. [Google Scholar] [CrossRef] [PubMed]
- Young, R. Phage lysis: Do we have the hole story yet? Curr. Opin. Microbiol. 2013, 16, 790–797. [Google Scholar] [CrossRef]
- Zhou, W.; Feng, Y.; Zong, Z. Two New Lytic Bacteriophages of the Myoviridae Family Against Carbapenem-Resistant Acinetobacter baumannii. Front. Microbiol. 2018, 9, 850. [Google Scholar] [CrossRef] [PubMed]
- Ibrahim, S.; Al-Saryi, N.; Al-Kadmy, I.M.S.; Aziz, S.N. Multidrug-resistant Acinetobacter baumannii as an emerging concern in hospitals. Mol. Biol. Rep. 2021, 48, 6987–6998. [Google Scholar] [CrossRef]
- Liu, X.; Qin, P.; Wen, H.; Wang, W.; Huo, Q.; Li, Q.; Zhao, J. Sex differences in Acinetobacter baumannii infections: A comprehensive analysis of antibiotic resistance patterns in Hebei Province, China. Am. J. Infect. Control 2025, in press. [Google Scholar] [CrossRef]
- Hu, M.; Sun, H.; Xu, Y.; Xu, X. Antimicrobial susceptibility and genetic characteristics of multi-drug resistant Acinetobacter baumannii isolates in Northwest China. Front. Microbiol. 2024, 15, 1293725. [Google Scholar] [CrossRef]
- Lob, S.H.; Hoban, D.J.; Sahm, D.F.; Badal, R.E. Regional differences and trends in antimicrobial susceptibility of Acinetobacter baumannii. Int. J. Antimicrob. Agents 2016, 47, 317–323. [Google Scholar] [CrossRef]
- Rima, M.; Oueslati, S.; Dabos, L.; Daaboul, D.; Mallat, H.; Bou Raad, E.; Achkar, M.; Mawlawi, O.; Bernabeu, S.; Bonnin, R.A.; et al. Prevalence and Molecular Mechanisms of Carbapenem Resistance among Gram-Negative Bacilli in Three Hospitals of Northern Lebanon. Antibiotics 2022, 11, 1295. [Google Scholar] [CrossRef] [PubMed]
- Ghosh, C.; Sarkar, P.; Issa, R.; Haldar, J. Alternatives to Conventional Antibiotics in the Era of Antimicrobial Resistance. Trends Microbiol. 2019, 27, 323–338. [Google Scholar] [CrossRef]
- Nelson, D.C.; Schmelcher, M.; Rodriguez-Rubio, L.; Klumpp, J.; Pritchard, D.G.; Dong, S.; Donovan, D.M. Endolysins as antimicrobials. Adv. Virus Res. 2012, 83, 299–365. [Google Scholar] [CrossRef] [PubMed]
- Yuan, Y.; Li, X.; Wang, L.; Li, G.; Cong, C.; Li, R.; Cui, H.; Murtaza, B.; Xu, Y. The endolysin of the Acinetobacter baumannii phage vB_AbaP_D2 shows broad antibacterial activity. Microb. Biotechnol. 2021, 14, 403–418. [Google Scholar] [CrossRef]
- Park, Y.; Lim, J.A.; Kong, M.; Ryu, S.; Rhee, S. Structure of bacteriophage SPN1S endolysin reveals an unusual two-module fold for the peptidoglycan lytic and binding activity. Mol. Microbiol. 2014, 92, 316–325. [Google Scholar] [CrossRef] [PubMed]
- Abdelkader, K.; Gutiérrez, D.; Grimon, D.; Ruas-Madiedo, P.; Lood, C.; Lavigne, R.; Safaan, A.; Khairalla, A.S.; Gaber, Y.; Dishisha, T.; et al. Lysin LysMK34 of Acinetobacter baumannii Bacteriophage PMK34 Has a Turgor Pressure-Dependent Intrinsic Antibacterial Activity and Reverts Colistin Resistance. Appl. Environ. Microbiol. 2020, 86, e01311-20. [Google Scholar] [CrossRef]
- Behera, M.; Singh, G.; De, S.; Ghorai, S.M. Molecular Docking and Molecular Dynamics Simulation Insight of Amidase_2 Endolysin Domain as an Antifungal Enzyme. Chem. Afr. 2024, 8, 487–503. [Google Scholar] [CrossRef]
- Blasco, L.; Ambroa, A.; Trastoy, R.; Bleriot, I.; Moscoso, M.; Fernández-Garcia, L.; Perez-Nadales, E.; Fernández-Cuenca, F.; Torre-Cisneros, J.; Oteo-Iglesias, J.; et al. In vitro and in vivo efficacy of combinations of colistin and different endolysins against clinical strains of multi-drug resistant pathogens. Sci. Rep. 2020, 10, 7163. [Google Scholar] [CrossRef] [PubMed]
- Chu, J.J.K.; Poh, W.H.; Hasnuddin, N.T.B.; Hew, E.Y.; Dam, L.C.; Sahili, A.E.; Rice, S.A.; Goh, B.C. Novel Phage Lysin Abp013 against Acinetobacter baumannii. Antibiotics 2022, 11, 169. [Google Scholar] [CrossRef]
- Sitthisak, S.; Manrueang, S.; Khongfak, S.; Leungtongkam, U.; Thummeepak, R.; Thanwisai, A.; Burton, N.; Dhanoa, G.K.; Tsapras, P.; Sagona, A.P. Antibacterial activity of vB_AbaM_PhT2 phage hydrophobic amino acid fusion endolysin, combined with colistin against Acinetobacter baumannii. Sci. Rep. 2023, 13, 7470. [Google Scholar] [CrossRef]
- Sisson, H.M.; Jackson, S.A.; Fagerlund, R.D.; Warring, S.L.; Fineran, P.C. Gram-negative endolysins: Overcoming the outer membrane obstacle. Curr. Opin. Microbiol. 2024, 78, 102433. [Google Scholar] [CrossRef]
- Li, P.; Shen, M.; Ma, W.; Zhou, X.; Shen, J. LysZX4-NCA, a new endolysin with broad-spectrum antibacterial activity for topical treatment. Virus Res. 2024, 340, 199296. [Google Scholar] [CrossRef] [PubMed]
- Oliveira, H.; Thiagarajan, V.; Walmagh, M.; Sillankorva, S.; Lavigne, R.; Neves-Petersen, M.T.; Kluskens, L.D.; Azeredo, J. A thermostable Salmonella phage endolysin, Lys68, with broad bactericidal properties against gram-negative pathogens in presence of weak acids. PLoS ONE 2014, 9, e108376. [Google Scholar] [CrossRef] [PubMed]
- Huang, G.; Shen, X.; Gong, Y.; Dong, Z.; Zhao, X.; Shen, W.; Wang, J.; Hu, F.; Peng, Y. Antibacterial properties of Acinetobacter baumannii phage Abp1 endolysin (PlyAB1). BMC Infect. Dis. 2014, 14, 681. [Google Scholar] [CrossRef]
- Zhang, S.; Chang, Y.; Zhang, Q.; Yuan, Y.; Qi, Q.; Lu, X. Characterization of Salmonella endolysin XFII produced by recombinant Escherichia coli and its application combined with chitosan in lysing Gram-negative bacteria. Microb. Cell Fact. 2022, 21, 171. [Google Scholar] [CrossRef]
- Chu, D.; Lan, J.; Liang, L.; Xia, K.; Li, L.; Yang, L.; Liu, H.; Zhang, T. The antibacterial activity of a novel highly thermostable endolysin, LysKP213, against Gram-negative pathogens is enhanced when combined with outer membrane permeabilizing agents. Front. Microbiol. 2024, 15, 1454618. [Google Scholar] [CrossRef]
- Lim, J.A.; Shin, H.; Heu, S.; Ryu, S. Exogenous lytic activity of SPN9CC endolysin against gram-negative bacteria. J. Microbiol. Biotechnol. 2014, 24, 803–811. [Google Scholar] [CrossRef]
- Briers, Y.; Walmagh, M.; Lavigne, R. Use of bacteriophage endolysin EL188 and outer membrane permeabilizers against Pseudomonas aeruginosa. J. Appl. Microbiol. 2011, 110, 778–785. [Google Scholar] [CrossRef]
- Heselpoth, R.D.; Euler, C.W.; Schuch, R.; Fischetti, V.A. Lysocins: Bioengineered Antimicrobials That Deliver Lysins across the Outer Membrane of Gram-Negative Bacteria. Antimicrob. Agents Chemother. 2019, 63, e00342-19. [Google Scholar] [CrossRef]
- Chen, X.; Liu, M.; Zhang, P.; Leung, S.S.Y.; Xia, J. Membrane-Permeable Antibacterial Enzyme against Multidrug-Resistant Acinetobacter baumannii. ACS Infect. Dis. 2021, 7, 2192–2204. [Google Scholar] [CrossRef]
- Lim, J.; Jang, J.; Myung, H.; Song, M. Eradication of drug-resistant Acinetobacter baumannii by cell-penetrating peptide fused endolysin. J. Microbiol. 2022, 60, 859–866. [Google Scholar] [CrossRef] [PubMed]
- Lood, R.; Winer, B.Y.; Pelzek, A.J.; Diez-Martinez, R.; Thandar, M.; Euler, C.W.; Schuch, R.; Fischetti, V.A. Novel phage lysin capable of killing the multidrug-resistant gram-negative bacterium Acinetobacter baumannii in a mouse bacteremia model. Antimicrob. Agents Chemother. 2015, 59, 1983–1991. [Google Scholar] [CrossRef] [PubMed]
- Raz, A.; Serrano, A.; Hernandez, A.; Euler, C.W.; Fischetti, V.A. Isolation of Phage Lysins That Effectively Kill Pseudomonas aeruginosa in Mouse Models of Lung and Skin Infection. Antimicrob. Agents Chemother. 2019, 63, e00024-19. [Google Scholar] [CrossRef] [PubMed]
- Jeong, T.H.; Hong, H.W.; Kim, M.S.; Song, M.; Myung, H. Characterization of Three Different Endolysins Effective against Gram-Negative Bacteria. Viruses 2023, 15, 679. [Google Scholar] [CrossRef]
- Shavrina, M.S.; Zimin, A.A.; Molochkov, N.V.; Chernyshov, S.V.; Machulin, A.V.; Mikoulinskaia, G.V. In vitro study of the antibacterial effect of the bacteriophage T5 thermostable endolysin on Escherichia coli cells. J. Appl. Microbiol. 2016, 121, 1282–1290. [Google Scholar] [CrossRef]
- Walmagh, M.; Briers, Y.; dos Santos, S.B.; Azeredo, J.; Lavigne, R. Characterization of modular bacteriophage endolysins from Myoviridae phages OBP, 201φ2-1 and PVP-SE1. PLoS ONE 2012, 7, e36991. [Google Scholar] [CrossRef]
- Yang, Y.; Le, S.; Shen, W.; Chen, Q.; Huang, Y.; Lu, S.; Tan, Y.; Li, M.; Hu, F.; Li, Y. Antibacterial Activity of a Lytic Enzyme Encoded by Pseudomonas aeruginosa Double Stranded RNA Bacteriophage phiYY. Front. Microbiol. 2018, 9, 1778. [Google Scholar] [CrossRef]
- Schmelcher, M.; Waldherr, F.; Loessner, M.J. Listeria bacteriophage peptidoglycan hydrolases feature high thermoresistance and reveal increased activity after divalent metal cation substitution. Appl. Microbiol. Biotechnol. 2012, 93, 633–643. [Google Scholar] [CrossRef]
- Li, Y.; Luo, K.; Jiang, C.; Zhang, Y.; Yang, Y.; Yao, Y.; Li, H.; Gan, F.; Tang, X.-F.; Tang, B. Enzymatic property and stabilization mechanism of LysBT1, a novel polyextremotolerant endolysin with a C-terminal S-layer homology domain. Appl. Environ. Microbiol. 2025, 91, e00867-25. [Google Scholar] [CrossRef]
- Wang, C.; Zhao, J.; Lin, Y.; Lwin, S.Z.C.; El-Telbany, M.; Masuda, Y.; Honjoh, K.I.; Miyamoto, T. Characterization of Two Novel Endolysins from Bacteriophage PEF1 and Evaluation of Their Combined Effects on the Control of Enterococcus faecalis Planktonic and Biofilm Cells. Antibiotics 2024, 13, 884. [Google Scholar] [CrossRef]
- Shen, K.-S.; Shu, M.; Tang, M.-X.; Yang, W.-Y.; Wang, S.-C.; Zhong, C.; Wu, G.-P. Molecular cloning, expression and characterization of a bacteriophage JN01 endolysin and its antibacterial activity against E. coli O157:H7. LWT 2022, 165, 113705. [Google Scholar] [CrossRef]
- Son, B.; Yun, J.; Lim, J.A.; Shin, H.; Heu, S.; Ryu, S. Characterization of LysB4, an endolysin from the Bacillus cereus-infecting bacteriophage B4. BMC Microbiol. 2012, 12, 33. [Google Scholar] [CrossRef] [PubMed]
- Plotka, M.; Kaczorowska, A.K.; Morzywolek, A.; Makowska, J.; Kozlowski, L.P.; Thorisdottir, A.; Skírnisdottir, S.; Hjörleifsdottir, S.; Fridjonsson, O.H.; Hreggvidsson, G.O.; et al. Biochemical Characterization and Validation of a Catalytic Site of a Highly Thermostable Ts2631 Endolysin from the Thermus scotoductus Phage vB_Tsc2631. PLoS ONE 2015, 10, e0137374. [Google Scholar] [CrossRef]
- Yan, Q.; Zhang, S.; Li, S.; Wang, G.; Zhang, A.; Jin, T.; Zhang, Y.; Lv, Q.; Xiao, M.; Sun, Y.; et al. Cultivation and Genomic Characterization of the Bile Bacterial Species From Cholecystitis Patients. Front. Microbiol. 2021, 12, 739621. [Google Scholar] [CrossRef] [PubMed]
- Abhari, S.S.; Azizi, O.; Modiri, L.; Aslani, M.M.; Assmar, M.; Fereshteh, S.; Badmasti, F. Two new rapid PCR-based methods for identification of Acinetobacter baumannii isolated from clinical samples. Mol. Cell Probes 2021, 58, 101732. [Google Scholar] [CrossRef]
- Asadian, M.; Azimi, L.; Alinejad, F.; Ostadi, Y.; Lari, A.R. Molecular Characterization of Acinetobacter baumannii Isolated from Ventilator-Associated Pneumonia and Burn Wound Colonization by Random Amplified Polymorphic DNA Polymerase Chain Reaction and the Relationship between Antibiotic Susceptibility and Biofilm Production. Adv. Biomed. Res. 2019, 8, 58. [Google Scholar] [CrossRef] [PubMed]
- Hudzicki, J. Kirby-Bauer Disk Diffusion Susceptibility Test Protocol; American Society for Microbiology: Washington, DC, USA, 2009. [Google Scholar]
- CLSI (Clinical and Laboratory Standards Institute). Performance Standards for Antimicrobial Susceptibility Testing; Clinical and Laboratory Standards Institute: Wayne, PA, USA, 2024. [Google Scholar]
- Haddad Kashani, H.; Fahimi, H.; Dasteh Goli, Y.; Moniri, R. A Novel Chimeric Endolysin with Antibacterial Activity against Methicillin-Resistant Staphylococcus aureus. Front. Cell Infect. Microbiol. 2017, 7, 290. [Google Scholar] [CrossRef]
- Soontarach, R.; Srimanote, P.; Arechanajan, B.; Nakkaew, A.; Voravuthikunchai, S.P.; Chusri, S. Characterization of a novel bacteriophage endolysin (LysAB1245) with extended lytic activity against distinct capsular types associated with Acinetobacter baumannii resistance. PLoS ONE 2024, 19, e0296453. [Google Scholar] [CrossRef] [PubMed]
- Khan, F.M.; Gondil, V.S.; Li, C.; Jiang, M.; Li, J.; Yu, J.; Wei, H.; Yang, H. A Novel Acinetobacter baumannii Bacteriophage Endolysin LysAB54 With High Antibacterial Activity Against Multiple Gram-Negative Microbes. Front. Cell Infect. Microbiol. 2021, 11, 637313. [Google Scholar] [CrossRef] [PubMed]

| Strains, Plasmid, Primers | Description, Characteristics, and Sequence | Origin and Reference |
|---|---|---|
| Strains | ||
| A. baumannii | 11 clinical isolates | Sputum samples (Microbiology lab, CH, DUT) |
| E. coli RW-29 S. aureus E. gallinarum HCD 28-1 | Pathogenic strain Pathogenic strain Pathogenic strain | CRC patient (Laboratory collection) (not published) ATCC 29213 Cholecystitis patient (Laboratory collection) [99] |
| E. coli BL21 (DE3) | For protein expression | Novagen, Madison, WI, USA |
| E. coli Top10 | For cloning | ThermoFisher Scientific, Waltham, MA, USA |
| Plasmid | ||
| pET-24b | E. coli expression vector, Kanr | Novagen, Madison, WI, USA |
| Primers | ||
| rpoB | ||
| Forward | 5′-CTGACTTGACGCGTGA-3′ | [100] |
| Reverse | 5′-TGTTTGAACCCATGAGC-3′ | |
| Gluconolactonase | ||
| Forward | 5-TTGGAGAATGCCCAACTTGG-3′ | [100] |
| Reverse | 5′-CCCGTCTTCGAGCGCAAC-3′ |
Disclaimer/Publisher’s Note: The statements, opinions and data contained in all publications are solely those of the individual author(s) and contributor(s) and not of MDPI and/or the editor(s). MDPI and/or the editor(s) disclaim responsibility for any injury to people or property resulting from any ideas, methods, instructions or products referred to in the content. |
© 2025 by the authors. Licensee MDPI, Basel, Switzerland. This article is an open access article distributed under the terms and conditions of the Creative Commons Attribution (CC BY) license (https://creativecommons.org/licenses/by/4.0/).
Share and Cite
Ullah, I.; Cui, S.; Yan, Q.; Ullah, H.; Sha, S.; Ma, Y. In Vitro Antibacterial Efficacy of Recombinant Phage-Derived Endolysin LysTAC1 Against Carbapenem-Resistant Acinetobacter baumannii. Antibiotics 2025, 14, 975. https://doi.org/10.3390/antibiotics14100975
Ullah I, Cui S, Yan Q, Ullah H, Sha S, Ma Y. In Vitro Antibacterial Efficacy of Recombinant Phage-Derived Endolysin LysTAC1 Against Carbapenem-Resistant Acinetobacter baumannii. Antibiotics. 2025; 14(10):975. https://doi.org/10.3390/antibiotics14100975
Chicago/Turabian StyleUllah, Inam, Song Cui, Qiulong Yan, Hayan Ullah, Shanshan Sha, and Yufang Ma. 2025. "In Vitro Antibacterial Efficacy of Recombinant Phage-Derived Endolysin LysTAC1 Against Carbapenem-Resistant Acinetobacter baumannii" Antibiotics 14, no. 10: 975. https://doi.org/10.3390/antibiotics14100975
APA StyleUllah, I., Cui, S., Yan, Q., Ullah, H., Sha, S., & Ma, Y. (2025). In Vitro Antibacterial Efficacy of Recombinant Phage-Derived Endolysin LysTAC1 Against Carbapenem-Resistant Acinetobacter baumannii. Antibiotics, 14(10), 975. https://doi.org/10.3390/antibiotics14100975

